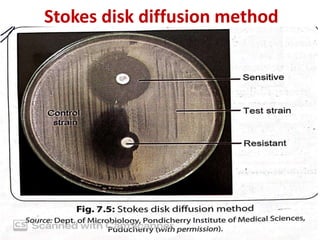
Stokes disk diffusion method

Antimicrobial susceptibility testing (AST) involves standardizing test conditions to determine if bacteria are susceptible, intermediate, or resistant to antimicrobial agents. There are three main methods: broth microdilution directly measures minimum inhibitory concentrations; agar dilution tests bacteria on agar plates containing serial drug dilutions; and disk diffusion examines growth inhibition zones around disks containing drugs. Commercial systems automate these methods. AST guides effective antimicrobial selection and resistance monitoring.